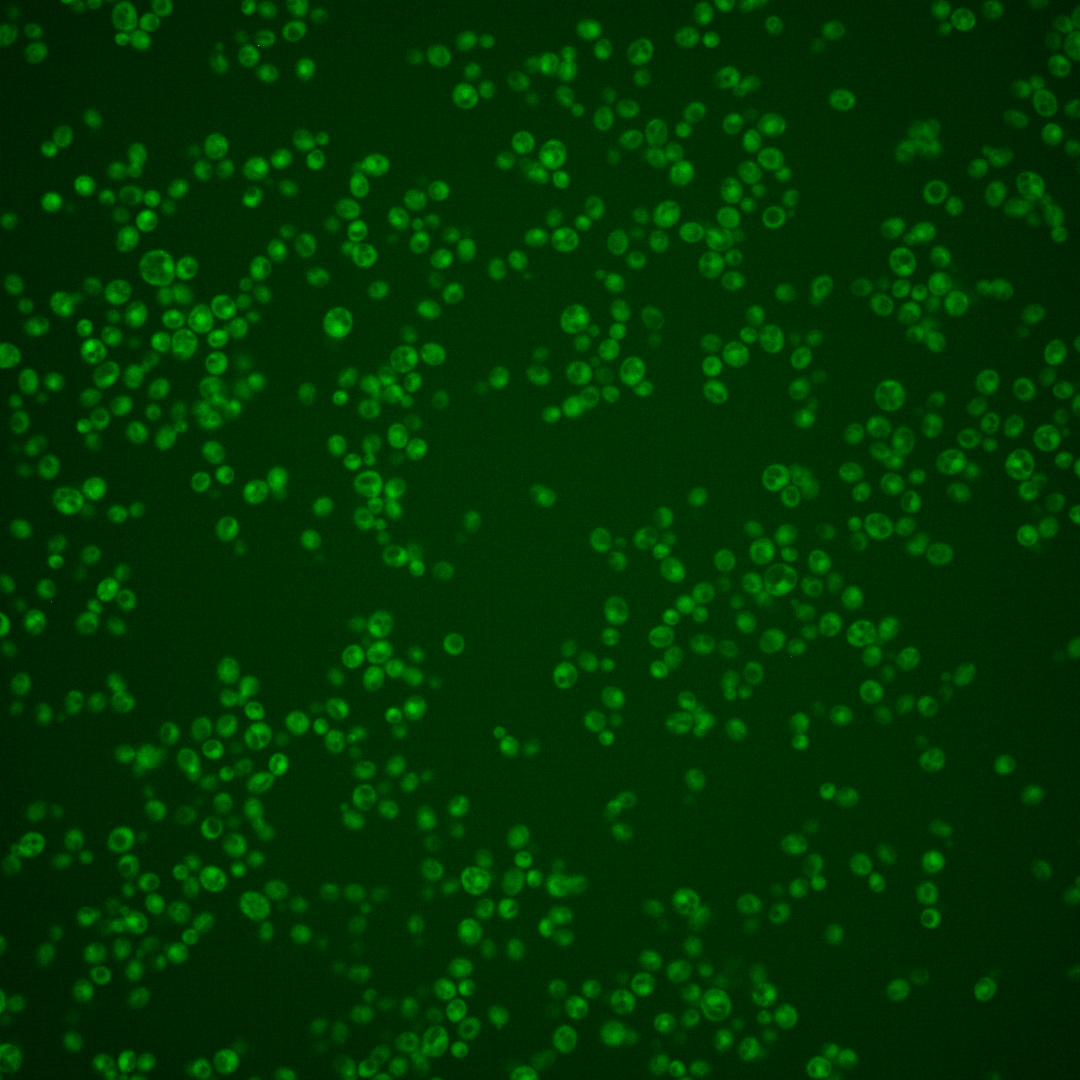

| Standard name | |
|---|---|
| Human Ortholog | |
| Description | UBX domain-containing protein that interacts with Cdc48p; ubiquitin regulatory X is also known as UBX |
Micrographs




















































































Sub-cellular Localization
Yeast GFP Assignment
Protein Abundance
Localization Change
External localization resources
| ensLOC | DeepLoc | |||||||||||||||||||||||
|---|---|---|---|---|---|---|---|---|---|---|---|---|---|---|---|---|---|---|---|---|---|---|---|---|
| Localization | WT1 | WT2 | WT3 | RAP60 | RAP140 | RAP220 | RAP300 | RAP380 | RAP460 | RAP540 | RAP620 | RAP700 | HU80 | HU120 | HU160 | rpd3Δ_1 | rpd3Δ_2 | rpd3Δ_3 | WT1 | WT2 | WT3 | AF100 | AF140 | AF180 |
| Cortical Patches | 0 | 0 | 0 | 0 | 0 | 0 | 0 | 0 | 0 | 0 | 0 | 0 | 0 | 0 | 0 | – | 0 | 0 | 3 | 5 | 6 | 1 | 2 | 4 |
| Bud | 1 | 0 | 2 | 0 | 3 | 1 | 2 | 10 | 10 | 8 | 7 | 9 | 1 | 0 | 0 | – | 0 | 0 | 1 | 9 | 1 | 1 | 3 | 4 |
| Bud Neck | 0 | 1 | 3 | 1 | 4 | 3 | 3 | 13 | 2 | 2 | 2 | 2 | 2 | 0 | 0 | – | 0 | 1 | 2 | 2 | 3 | 1 | 1 | 3 |
| Bud Site | 0 | 0 | 0 | 0 | 0 | 0 | 1 | 1 | 3 | 0 | 1 | 0 | 0 | 0 | 0 | – | 0 | 0 | – | – | – | – | – | – |
| Cell Periphery | 0 | 5 | 0 | 2 | 1 | 2 | 0 | 2 | 0 | 4 | 0 | 0 | 3 | 1 | 1 | – | 1 | 2 | 1 | 2 | 3 | 0 | 2 | 2 |
| Cytoplasm | 259 | 462 | 291 | 197 | 265 | 210 | 276 | 222 | 271 | 275 | 159 | 213 | 234 | 407 | 388 | – | 158 | 129 | 203 | 388 | 183 | 144 | 187 | 235 |
| Endoplasmic Reticulum | 1 | 5 | 1 | 0 | 0 | 0 | 0 | 2 | 1 | 0 | 5 | 0 | 1 | 0 | 2 | – | 14 | 10 | 2 | 0 | 2 | 0 | 0 | 2 |
| Endosome | 0 | 2 | 0 | 0 | 0 | 0 | 0 | 0 | 0 | 0 | 0 | 0 | 1 | 0 | 0 | – | 1 | 3 | 1 | 9 | 2 | 1 | 4 | 3 |
| Golgi | 0 | 1 | 0 | 1 | 0 | 0 | 0 | 0 | 0 | 1 | 0 | 0 | 0 | 0 | 4 | – | 1 | 1 | 2 | 1 | 0 | 0 | 1 | 0 |
| Mitochondria | 37 | 2 | 3 | 20 | 20 | 65 | 111 | 112 | 138 | 156 | 177 | 158 | 0 | 0 | 0 | – | 3 | 4 | 37 | 30 | 51 | 13 | 16 | 12 |
| Nucleus | 0 | 1 | 0 | 0 | 1 | 0 | 0 | 1 | 1 | 0 | 0 | 1 | 0 | 0 | 2 | – | 2 | 0 | 0 | 2 | 0 | 0 | 0 | 0 |
| Nuclear Periphery | 1 | 0 | 0 | 0 | 1 | 1 | 0 | 0 | 0 | 0 | 1 | 0 | 0 | 0 | 0 | – | 0 | 0 | 0 | 1 | 0 | 0 | 0 | 0 |
| Nucleolus | 1 | 0 | 0 | 1 | 0 | 0 | 0 | 0 | 0 | 0 | 0 | 1 | 0 | 0 | 0 | – | 2 | 1 | 1 | 0 | 0 | 0 | 0 | 0 |
| Peroxisomes | 0 | 0 | 0 | 0 | 0 | 0 | 0 | 0 | 0 | 0 | 0 | 0 | 0 | 0 | 0 | – | 0 | 0 | 1 | 0 | 0 | 0 | 0 | 0 |
| SpindlePole | 1 | 0 | 1 | 3 | 1 | 1 | 8 | 6 | 12 | 7 | 5 | 9 | 0 | 0 | 0 | – | 0 | 2 | 5 | 11 | 2 | 2 | 4 | 3 |
| Vac/Vac Membrane | 0 | 2 | 1 | 0 | 5 | 0 | 1 | 0 | 1 | 11 | 1 | 0 | 0 | 0 | 0 | – | 11 | 4 | 5 | 5 | 7 | 1 | 2 | 5 |
| Unique Cell Count | 278 | 474 | 294 | 205 | 277 | 245 | 343 | 317 | 363 | 362 | 290 | 316 | 239 | 407 | 394 | 169 | 137 | 276 | 481 | 278 | 174 | 238 | 284 | |
| Labelled Cell Count | 301 | 481 | 302 | 225 | 301 | 283 | 402 | 369 | 439 | 464 | 358 | 393 | 242 | 408 | 397 | 193 | 157 | 276 | 481 | 278 | 174 | 238 | 284 | |
Yeast GFP Assignment
Protein Abundance
| Screen | WT1 | WT2 | WT3 | RAP60 | RAP140 | RAP220 | RAP300 | RAP380 | RAP460 | RAP540 | RAP620 | RAP700 | HU80 | HU120 | HU160 | rpd3Δ_1 | rpd3Δ_2 | rpd3Δ_3 | AF100 | AF140 | AF180 |
|---|---|---|---|---|---|---|---|---|---|---|---|---|---|---|---|---|---|---|---|---|---|
| Mean Cell GFP Intensity (1e-4) | 3.1 | 4.0 | 3.2 | 3.0 | 3.2 | 2.9 | 2.3 | 2.5 | 2.7 | 2.4 | 2.5 | 2.4 | 4.3 | 4.0 | 4.3 | 4.6 | 5.9 | 5.8 | 3.4 | 3.9 | 4.4 |
| Std Deviation (1e-4) | 0.7 | 1.0 | 0.9 | 1.0 | 1.4 | 1.2 | 1.0 | 0.8 | 1.2 | 0.9 | 0.8 | 1.2 | 1.2 | 1.1 | 1.4 | 1.6 | 1.9 | 2.3 | 1.0 | 1.6 | 1.1 |
| Intensity Change (Log2) | – | – | – | -0.1 | -0.02 | -0.18 | -0.47 | -0.36 | -0.26 | -0.46 | -0.39 | -0.44 | 0.4 | 0.3 | 0.4 | 0.5 | 0.86 | 0.83 | 0.08 | 0.27 | 0.43 |
Localization Change
| Localization | RAP60 | RAP140 | RAP220 | RAP300 | RAP380 | RAP460 | RAP540 | RAP620 | RAP700 | HU80 | HU120 | HU160 | rpd3Δ_1 | rpd3Δ_2 | rpd3Δ_3 |
|---|---|---|---|---|---|---|---|---|---|---|---|---|---|---|---|
| Actin | – | – | – | – | – | – | – | – | – | – | – | – | – | – | – |
| Bud | – | – | – | – | – | – | – | – | – | – | – | – | – | – | – |
| Bud Neck | – | – | – | – | – | – | – | – | – | – | – | – | – | – | – |
| Bud Site | – | – | – | – | – | – | – | – | – | – | – | – | – | – | – |
| Cell Periphery | – | – | – | – | – | – | – | – | – | – | – | – | – | – | – |
| Cyto | – | – | – | – | – | – | – | – | – | – | – | – | – | – | – |
| Endoplasmic Reticulum | – | – | – | – | – | – | – | – | – | – | – | – | – | – | – |
| Endosome | – | – | – | – | – | – | – | – | – | – | – | – | – | – | – |
| Golgi | – | – | – | – | – | – | – | – | – | – | – | – | – | – | – |
| Mitochondria | – | – | – | – | – | – | – | – | – | – | – | – | – | – | – |
| Nuclear Periphery | – | – | – | – | – | – | – | – | – | – | – | – | – | – | – |
| Nuc | – | – | – | – | – | – | – | – | – | – | – | – | – | – | – |
| Nucleolus | – | – | – | – | – | – | – | – | – | – | – | – | – | – | – |
| Peroxisomes | – | – | – | – | – | – | – | – | – | – | – | – | – | – | – |
| SpindlePole | – | – | – | – | – | – | – | – | – | – | – | – | – | – | – |
| Vac | – | – | – | – | – | – | – | – | – | – | – | – | – | – | – |
| Cortical Patches | – | – | – | – | – | – | – | – | – | – | – | – | – | – | – |
| Cytoplasm | – | – | – | – | – | – | – | – | – | – | – | – | – | – | – |
| Nucleus | – | – | – | – | – | – | – | – | – | – | – | – | – | – | – |
| Vacuole | – | – | – | – | – | – | – | – | – | – | – | – | – | – | – |
External localization resources
Images






























Protein Concentration and Protein Localization Data
| R1 | R2 | R3 | ||||||||||||||||
|---|---|---|---|---|---|---|---|---|---|---|---|---|---|---|---|---|---|---|
| G1 Pre-START | G1 Post-START | S/G2 | Metaphase | Anaphase | Telophase | G1 Pre-START | G1 Post-START | S/G2 | Metaphase | Anaphase | Telophase | G1 Pre-START | G1 Post-START | S/G2 | Metaphase | Anaphase | Telophase | |
| Concentration | 2.0863 | 1.8472 | 1.6544 | 1.4164 | 1.4978 | 1.8636 | 2.3215 | 2.2827 | 2.23 | 2.6572 | 2.4509 | 1.9978 | 2.4757 | 2.3084 | 2.311 | 2.1529 | 2.4985 | 2.6331 |
| Actin | 0.021 | 0.0008 | 0.0086 | 0.0043 | 0.013 | 0.0079 | 0.0476 | 0.0018 | 0.0432 | 0.025 | 0.0313 | 0.0017 | 0.025 | 0.0006 | 0.0073 | 0 | 0.0266 | 0.0043 |
| Bud | 0.0018 | 0.0034 | 0.0022 | 0 | 0.0035 | 0.0009 | 0.0037 | 0.0073 | 0.0007 | 0.0116 | 0.0042 | 0.002 | 0.0004 | 0.0016 | 0.0008 | 0 | 0.0038 | 0.0028 |
| Bud Neck | 0.0085 | 0.0002 | 0.0001 | 0.0025 | 0.0007 | 0.0011 | 0.0047 | 0.0008 | 0.0023 | 0.0012 | 0.0077 | 0.0023 | 0.0096 | 0.0004 | 0.003 | 0 | 0.0051 | 0.001 |
| Bud Periphery | 0.0075 | 0.002 | 0.0008 | 0.0001 | 0.0138 | 0.0014 | 0.0165 | 0.007 | 0.001 | 0.0149 | 0.0077 | 0.0034 | 0.0008 | 0.0023 | 0.0019 | 0 | 0.0099 | 0.0056 |
| Bud Site | 0.0084 | 0.0107 | 0.0023 | 0.0003 | 0.0012 | 0.0003 | 0.0114 | 0.03 | 0.0144 | 0.0141 | 0.0075 | 0.0005 | 0.0054 | 0.0127 | 0.0013 | 0 | 0.0143 | 0.0021 |
| Cell Periphery | 0.0009 | 0.0004 | 0.0002 | 0.0001 | 0.0002 | 0.0002 | 0.0009 | 0.0003 | 0.0003 | 0.0033 | 0.0008 | 0.0001 | 0.0003 | 0.0005 | 0.0004 | 0 | 0.0018 | 0.0001 |
| Cytoplasm | 0.0244 | 0.0314 | 0.0239 | 0.0194 | 0.0445 | 0.038 | 0.0118 | 0.0099 | 0.0103 | 0.0074 | 0.0091 | 0.0198 | 0.0151 | 0.0236 | 0.0187 | 0.0455 | 0.0213 | 0.0217 |
| Cytoplasmic Foci | 0.0134 | 0.0071 | 0.0069 | 0.0027 | 0.0083 | 0.005 | 0.0095 | 0.0038 | 0.0067 | 0.0226 | 0.0074 | 0.0083 | 0.0232 | 0.0018 | 0.0068 | 0.0025 | 0.0036 | 0.0118 |
| Eisosomes | 0.0008 | 0.0002 | 0.0002 | 0.0004 | 0.0002 | 0.0001 | 0.0006 | 0.0002 | 0.001 | 0.0019 | 0.0004 | 0.0001 | 0.0006 | 0.0002 | 0.0003 | 0.0001 | 0.0004 | 0.0001 |
| Endoplasmic Reticulum | 0.0074 | 0.0006 | 0.0006 | 0.0003 | 0.0021 | 0.0005 | 0.0032 | 0.0002 | 0.0011 | 0.004 | 0.0007 | 0.0011 | 0.0022 | 0.0004 | 0.0004 | 0.0002 | 0.0006 | 0.0004 |
| Endosome | 0.0077 | 0.0028 | 0.0027 | 0.001 | 0.0087 | 0.0014 | 0.008 | 0.0001 | 0.0048 | 0.0044 | 0.0151 | 0.0019 | 0.0051 | 0.0003 | 0.0009 | 0.0027 | 0.0009 | 0.0009 |
| Golgi | 0.004 | 0.0002 | 0.0006 | 0.0004 | 0.0012 | 0.0005 | 0.0033 | 0.0001 | 0.0027 | 0.0035 | 0.0118 | 0.0006 | 0.0018 | 0.0002 | 0.0007 | 0.0001 | 0.0017 | 0.0002 |
| Lipid Particles | 0.0036 | 0.0003 | 0.0013 | 0.0008 | 0.0019 | 0.0004 | 0.0039 | 0.0002 | 0.0053 | 0.0071 | 0.0059 | 0.0006 | 0.0023 | 0.0001 | 0.0018 | 0.0001 | 0.0033 | 0.0005 |
| Mitochondria | 0.0062 | 0.0029 | 0.001 | 0.0003 | 0.0012 | 0.0009 | 0.0018 | 0.0008 | 0.0027 | 0.0038 | 0.0136 | 0.0007 | 0.0012 | 0.0014 | 0.0021 | 0.0001 | 0.0027 | 0.0018 |
| None | 0.8431 | 0.9157 | 0.9357 | 0.9518 | 0.8493 | 0.9383 | 0.8369 | 0.9226 | 0.877 | 0.8462 | 0.8392 | 0.9479 | 0.8708 | 0.9501 | 0.935 | 0.9472 | 0.8949 | 0.9374 |
| Nuclear Periphery | 0.0164 | 0.0019 | 0.0009 | 0.0008 | 0.0235 | 0.0006 | 0.0079 | 0.0003 | 0.0036 | 0.0017 | 0.001 | 0.0014 | 0.015 | 0.0002 | 0.0007 | 0.0001 | 0.0003 | 0.0036 |
| Nucleolus | 0.0029 | 0.0016 | 0.0005 | 0.0015 | 0.001 | 0.0002 | 0.0026 | 0.0019 | 0.0015 | 0.0012 | 0.0014 | 0.0011 | 0.001 | 0.0004 | 0.0011 | 0 | 0.0005 | 0.0006 |
| Nucleus | 0.0103 | 0.0048 | 0.0012 | 0.0014 | 0.007 | 0.0005 | 0.0094 | 0.0028 | 0.0022 | 0.0015 | 0.0016 | 0.0018 | 0.0043 | 0.0016 | 0.0063 | 0.0001 | 0.0008 | 0.001 |
| Peroxisomes | 0.0023 | 0.0003 | 0.006 | 0.0005 | 0.0036 | 0.0003 | 0.0067 | 0.0006 | 0.0065 | 0.0186 | 0.0054 | 0.0003 | 0.0071 | 0.0002 | 0.0052 | 0 | 0.0063 | 0.0013 |
| Punctate Nuclear | 0.006 | 0.0096 | 0.0036 | 0.0112 | 0.0125 | 0.001 | 0.007 | 0.0087 | 0.0118 | 0.0035 | 0.0045 | 0.0031 | 0.0076 | 0.0007 | 0.0046 | 0.0001 | 0.0005 | 0.0023 |
| Vacuole | 0.0027 | 0.002 | 0.0005 | 0.0001 | 0.0018 | 0.0003 | 0.0019 | 0.0005 | 0.0006 | 0.002 | 0.0223 | 0.001 | 0.0006 | 0.0006 | 0.0006 | 0.001 | 0.0006 | 0.0003 |
| Vacuole Periphery | 0.0008 | 0.001 | 0.0001 | 0.0001 | 0.0008 | 0.0001 | 0.0006 | 0.0001 | 0.0003 | 0.0005 | 0.0014 | 0.0003 | 0.0006 | 0.0001 | 0.0001 | 0.0002 | 0.0001 | 0.0002 |
Sequencing Data
| R1 | R2 | |||||||||
|---|---|---|---|---|---|---|---|---|---|---|
| G1 Post-START | S/G2 | Metaphase | Anaphase | Telophase | G1 Post-START | S/G2 | Metaphase | Anaphase | Telophase | |
| Gene Expression | 9.9108 | 15.7505 | 15.5834 | 17.1155 | 12.3739 | 11.7397 | 18.9113 | 23.0645 | 18.7021 | 15.7292 |
| Translational Efficiency | 2.2624 | 1.641 | 1.7339 | 1.485 | 1.6226 | 2.4421 | 1.435 | 1.4554 | 1.7107 | 1.455 |
Hit Data
| Dataset | Hit |
|---|---|
| Protein Concentration | ✘ |
| Protein Localization | ✘ |
| Gene Expression | ✔ |
| Translational Efficiency | ✘ |
Endocytosis
| Temp | Actin Patch (Sac6-tdTomato) | Cortical Patch (Sla1-GFP) | Late Endosome (Snf7-GFP) | Vacuole (Vph1-GFP) |
|---|---|---|---|---|
| 37℃ | ||||
| RT |
Cell Cycle Omics
CYCLoPs (Ubx5-GFP)
| Gene / Allele | Actin Patch (Sac6-tdTomato) | Cortical Patch (Sla1-GFP) | Late Endosome (Snf7-GFP) | Vacuole (Sac6-tdTomato) |
|---|
| Gene | Images |
|---|
| Gene | Images |
|---|
Images are not yet available
Images are not yet available